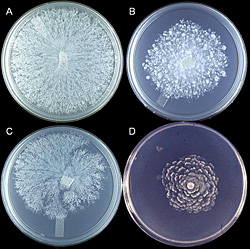
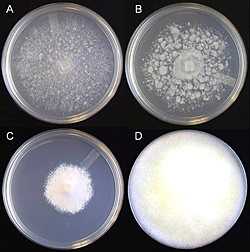

Black Shank of Tobacco
Phytophthora nicotianae Breda de Haan (synonyms: Phytophthora parasitica var. nicotianae, Phytophthora nicotianae var. nicotianae).
Tobacco: Nicotiana tabacum and N. rustica

Symptoms of black shank on flue-cured tobacco with characteristic yellowing and wilting of leaves.
Black shank can be a devastating root and crown rot disease of all types of tobacco, with losses in individual fields reaching 100%. The disease was first described from Indonesia in 1896, but has since spread to most major tobacco growing areas worldwide. Management requires an integrated approach based on cultural practices, host resistance, and soil applied fungicides.
Symptoms and Signs
Black shank affects tobacco plants at all growth stages. Disease begins on young seedlings or transplants (Figure 2) once soil temperatures rise above 20°C. The most common symptom of the disease is a root and crown rot (Figure 3), but the pathogen may also infect leaves if they come in contact with infested soil during rainy periods (Figure 4). Signs of the pathogen are infrequently observed on plant stems and around leaf lesions, but hyphae often are readily observed in pith tissues upon splitting of the stem (Figure 5). Since other fungi, especially species of Fusarium, are often present in these necrotic pith tissues, microscopic observation of pith cells may help confirm the presence of characteristic hyphae of Phytophthora (Figure 6). In the field, diseased plants are often associated with wet soil and losses may reach 100% in susceptible cultivars in years favorable for disease development (Figure 7).
 Figure 2 |
 Figure 3 |
 Figure 4 |
 Figure 5 |
 Figure 6 |
 Figure 7 |
Seedlings
Once infected, disease develops rapidly in young, succulent seedlings (Figure 8). In the field, symptoms begin as wilting, followed by yellowing of leaves, development of stem lesions, and plant death (Figures 2, 9). Depending on the size of the seedling, the plant may wilt and die within a few days or a few weeks. Infection of seedlings may occur directly on the stem as well as on the roots.
 Figure 8 |
 Figure 9 |
Roots
Root tips and wounds are the primary sites of infection by the pathogen (Figures 10, 11). Infected roots are initially water-soaked, then rapidly become necrotic (Figure 12). On susceptible varieties, lesion expansion progresses rapidly into larger roots until most or all of the root system is destroyed (Figures 3, 13). Colonization of root tissues in susceptible varieties proceeds rapidly and ultimately reaches the stem, resulting in the characteristic black shank symptom (Figure 14) and plant death.
 Figure 10 |
 Figure 11 |
 Figure 12 |
 Figure 13 |
 Figure 14 |
Stems
Stem lesions may continue up the stem 30 cm or more above the soil surface. A longitudinal cut through the stem reveals necrotic pith that is often separated into disks (Figure 15). The disking of the pith does not extend beyond the necrosis observed on the outside of the stem (Figure 16). Disking of the pith should not be used as a sole diagnostic feature of black shank, as other pathogens (Figure 17) and lightning injury (Figure 18) may also cause disking of the pith. The disking caused by lightning injury is not associated with necrosis initially and may extend the entire length of the stem.
 Figure 15 |
 Figure 16 |
 Figure 17 |
 Figure 18 |
 Figure 19 |
In addition to stem symptoms that develop as a result of root infection, infection also can occur directly on the stem. Infection of the stem occurs in old leaf traces that are buried during cultivation, which results in a stem lesion with little or no root necrosis (Figure 19). This symptom is sometimes referred to as stem black shank and may also result in plant death.
Leaves
Above ground symptoms of the stem and root rot phases of the disease begin as a temporary wilt that progresses into chlorosis of leaves and permanent wilting. The extent of chlorosis varies with the level of host resistance and the type of tobacco, with burley tobacco characteristically becoming a brighter yellow than flue-cured plants as the disease develops (Figures 1, 20).
 Figure 20 |
 Figure 21 |
Direct infection of leaves also may occur. Leaf infections may result from zoospores splashing onto the leaf surface or leaves coming into direct contact with infested soil. Lesions may remain brown to black or develop into circular, yellowish-to-brown spots that may reach up to 8 cm in diameter (Figure 4). The pathogen may grow down the petiole and into the stem (Figure 21), resulting in a stem lesion and plant death.
Pathogen Biology
Phytophthora nicotianae is a fungus-like organism in the Kingdom Straminipila (sometimes written as Stramenopila), phylum Oomycota, class Oomycetes. All stages of the organism are diploid; whereas, most true fungi are haploid. The organism can grow vegetatively at temperatures between 5°C and 37°C, with optimal growth occurring between 26°C and 32°C. Extended exposure to temperatures above 40°C is lethal to the organism.
Hyphae
Hyphae are hyaline (colorless, transparent), aseptate or coenocytic, and typically irregular in width (3-11µm) with few to numerous hyphal swellings (Figure 22). With age, hyphae acquire pseudosepta and colonies become light yellow. There is considerable morphological variation in colony type among isolates of P. nicotianae (Figure 23). The growth habit or colony morphology of an individual isolate may vary when grown on different culture media (Figure 24).
 Figure 22 |
Figure 23 |
Figure 24 |
Asexual reproduction
Sporangia are ovoid, pear-shaped, or spherical, and have very conspicuous papillae (Figure 25). Sizes of sporangia vary (18-70 x 14-39 µm) with isolate and the growth medium. Germination is either direct by production of hyphae or indirect by the production of five to 30 zoospores (Figure 26).
The zoospore is typically kidney-shaped, with a ventral groove from which two flagella emerge (Figure 27a). The posterior flagellum is whip-like and the anterior flagellum, a tinsel type, is shorter with hairs along its length. After settling down on a plat surface, zoospores encyst (produce a cell wall), and a single germ tube emerges from the spore (Figure 27b,c).
Chlamydospores are asexual, thick-walled spores produced at the tips (terminal) or in the middle (intercalary) of hyphae, and range from 13 to 60 µm in diameter, with walls approximately 1.5 µm thick (Figure 28). Chlamydospores serve as the primary survival propagule and as the primary inoculum that initiates epidemics. Survival for 4 to 6 years in soil has been reported.
 Figure 25 |
 Figure 26 |
 Figure 27 |
 Figure 28 |
Sexual reproduction
Phytophthora nicotianae is heterothallic, requiring two mating types (A1 and A2) for the production of oospores. Some single-strain cultures may develop oospores with age. Oospores are thick-walled, between 13 and 35 µm in diameter, almost filling the spherical oogonium cavity (between 15 and 64 µm in diameter). The antheridium is amphigynous (the oogonium grows through the antheridium at mating), spherical and remains permanently attached to the oogonium (Figure 29). It functions to contribute a nucleus during fertilization of the oogonium. Since many fields contain only one mating type and the oospores rarely germinate in culture, they are not thought to serve as a primary survival propagule or initiate infections that lead to epidemic development.
 Figure 29 |
Nomenclature
Currently, the most frequently used name for the black shank pathogen is Phytophthora nicotianae. Phytophthora parasitica var. nicotianae and Phytophthora nicotianae var. nicotianae have also been used, but their use is declining. See the Appendix below and Erwin and Ribeiro (1996) for a more detailed description of the taxonomy of this organism.
Host Range
The species P. nicotianae (synonym P. parasitica) has a very wide host range. However, there is much evidence of host specialization within isolates obtained from various hosts. Isolates from tobacco are generally considered to be important pathogens only on tobacco. Isolates of P. nicotianae from other hosts also have shown some level of host specialization as well. However, current understanding of the level of specialization in the species has not resulted in development of forma specialis, which is a sub-specific level of taxonomy based on host specialization used with some other plant pathogens. See Erwin and Ribeiro (1996) for a comprehensive list of hosts for this species.
Other Phytophthora spp.
In addition to P. nicotianae, other species of Phytophthora also can cause root rot of tobacco. Although black shank has not been reported from Brazil, the primary causal agent of the yellow stunt disease has been identified as P. glovera, a previously unreported Phytophthora spp. Other unidentified species of Phytophthora spp. have been isolated from diseased tobacco from Kentucky and North Carolina, but their contribution to disease losses has not yet been determined.
J. van Breda de Haan first described the pathogen as Phytophthora nicotianae in 1896 from Indonesia, but failed to submit a Latin description of the species. Additionally, his original drawings of the organism were inaccurate due to the presence of a contaminant, probably a Pythium species. Dastur also described the species from India in 1913, but gave it the name P. parasitica. In 1928, Ashby proposed that the name of all strains of this pathogen from tobacco be merged under the properly described name P. parasitica. Tucker in 1931 chose the name P. parasitica var. nicotianae to designate isolates based on pathogenicity, but pathogenicity should not have been used as a basis for variety because variety status is based on differences in morphology. Since isolates from tobacco display host specific pathogenicity, the use of forma specialis (f. sp.) would have been more appropriate, but again, studies have not been conducted to confirm the validity of this subspecific classification for tobacco isolates compared to isolates from other hosts. In fact, some isolates from tobacco will infect other plants.
It is generally agreed that P. parasitica is the more appropriate name, but the International Code of Botanical Nomenclature restricts its use. In 1963, Waterhouse replaced the name P. parasitica with P. nicotianae because it had priority despite errors in the original description. She further separated the species into P. nicotianae var. parasitica and P. nicotianae var. nicotianae based on morphological differences. Since 1963, multiple studies have shown that the morphology of these two varieties overlaps greatly and is not a valid basis for separating the species into varieties. Use of Phytophthora nicotianae is slowly gaining acceptance in the United States, including by tobacco pathologists; most pathologists in other countries have used this nomenclature for a number of years. We have used the name P. nicotianae in this disease lesson as this is the most widely recognized name for this organism at the current time.
Disease Cycle and Epidemiology
Disease Cycle
Black shank is a polycyclic disease. The number of cycles of infection per growing season and the extent of spread within a field are related to environmental conditions and the level and type of resistance in the cultivar planted. Chlamydospores in the soil and infested crop debris serve as the primary inoculum that initiates epidemics. Chlamydospores germinate in warm moist soil to produce one or several germ tubes that either directly infect the plant or produce a sporangium (Figure 30, 31).
 |
 |
| Figure 30 |
Figure 31 |
Saturated soil stimulates the release of motile zoospores from sporangia, and these are the primary infective propagules. Zoospores swim through saturated soil pores or move in surface water over greater distances (Figure 32). Active movement is directed toward nutrient gradients that occur around the root tips and wounds on the host plant (Figures 10, 11). Once the zoospore contacts the root surface, it encysts (produces a cell wall), loses the flagella, then germinates to form a germ tube that directly penetrates the host epidermis (Figure 27). The pathogen continues to colonize the roots and stem via hyphae (Figure 33). Sporangia serve as secondary inoculum, and can form within 24 hours of inoculation under moderate temperature and moist soil conditions (Figure 34). Root and stem colonization results in typical root rot and black shank symptoms (Figures 3, 13, 14). New chlamydospores form on and in the root as disease progresses (Figure 35) and can either germinate to initiate new infections or serve as a survival structure until the next tobacco crop is planted.
 Figure 32 |
 Figure 33 |
 Figure 34 |
 Figure 35 |
Disease Management
An effective disease management program for black shank requires an integration of cultural and chemical practices and planting resistant cultivars. The goal is to reduce pathogen populations in the soil that initiate epidemics of black shank. Since initial inoculum level is related to the development and severity of black shank epidemics, practices that reduce initial inoculum may greatly affect yield and quality of a tobacco crop.
Cultural practices
Cultural practices are vital to the long term management of black shank. Effective cultural practices include: planting on raised beds, which prevents or reduces duration of soil saturation required for zoospore movement in the root zone; crop rotation, which removes potential sources of nutrition for reproductive growth of the pathogen; and stalk and root destruction after harvest, which effectively removes the infected root system from the soil and suppresses inoculum buildup. Planting on raised beds (Figure 36) is not a common practice for many tobacco types and production regions, but it is widely used in flue-cured tobacco production.
Strains of P. nicotianae that cause black shank are host-specific, so rotation with any other crop plant is effective in reducing pathogen populations. Preliminary studies, however, indicate that long term survival in the absence of tobacco may also be related to limited colonization of certain weed hosts (Figure 37). The duration of the rotation should be at least two years, but even long rotations of four or more years will not totally eliminate the pathogen from many soils.
 Figure 36 |
 Figure 37 |
 Figure 38 |
Stalk and root destruction is the physical removal of the root system after the final harvest. Plants are plowed up and inverted to expose the root system to the sun. This practice is not used for all tobacco and soil types, but is effective in reducing late-season buildup of the pathogen on roots that remain alive long after leaves are harvested and stalks are cut. Root and stalk destruction also reduces populations of other pests and pathogens, especially nematodes such as root knot, Meloidogyne spp., that can greatly exacerbate black shank severity (Figure 38).
Soil chemistry greatly affects black shank development. The disease is favored by pH values greater than 6.2 and is suppressed at lower pH values. The suppression of the disease at low pH values has been related to the increased activity of aluminum (Al3+) that is present at low pH values, and which is highly toxic to Phytophthora spp. Since Al also is toxic to tobacco at pH values below 5.5, acidification of soil to reduce black shank severity, if attempted, should be done carefully so that phytotoxicity associated with high Al or Mn concentrations does not occur. Soil pH values between 5.5 and 6.0 provide favorable growing conditions for tobacco without providing highly conducive conditions for P. nicotianae.
Host Resistance
The most widely used method of control for black shank is planting of resistant varieties (Figure 39). Multiple sources and types of resistance are available to growers. The most widely deployed type is partial resistance. This type of resistance is present at levels that range from low to high. Continuous deployment of a high level of partial resistance results in the selection of more aggressive isolates of the pathogen.
 Figure 39 |
 Figure 40 |
Two single-gene sources of resistance have been incorporated into tobacco cultivars. Both of these genes provide complete resistance to race 0 of P. nicotianae, and no resistance to race 1 of the pathogen. Deployment of these two genes has resulted in race 1 of P. nicotianae becoming the dominant race of the pathogen present in many areas. Identification of races is based on the inoculation of a set of host differentials (Figure 40). Rotation of partial resistance and single-gene resistance is effective in slowing race shifts and prolonging the effectiveness of single gene resistance.
Chemical control
Chemical control can be effective when used in combination with other practices, but it is not highly effective when used in conjunction with a susceptible variety. The options for chemical control are limited to a single chemistry, with either metalaxyl or its near-identical twin mefenoxam used in single or multiple applications. Mefenoxam is twice as active as metalaxyl, but has the same mode of action. Application rates and time of application (preplant, at first cultivation, or four weeks after transplanting) vary with the level and type of host resistance used and the history of disease in the field. The use of soil fumigants such as chloropicrin may reduce pathogen populations, and fumigant nematicides such as 1,3-dichloropropene reduce nematode populations that enhance black shank incidence and severity.
Significance
The Dutch scientist J. van Breda de Haan first described black shank on cigar wrapper tobacco in Java (Indonesia) in 1896, two years after arriving in Sumatra as the chief of the laboratory for Deli tobacco. Since tobacco was introduced to Northern Sumatra in the 1860s by the Dutch, it is likely that black shank had been occurring for years prior to the report in 1896. The native hosts of P. nicotianae in Sumatra are unknown, but it also is likely that the pathogen was surviving (causing disease?) on other plants prior to encountering its new tobacco host. Van Breda de Haan also reported P. nicotianae from Amaranthus in Sumatra, and other researchers have reported that tobacco isolates attack multiple plants. However, tobacco appears to be the only economically important host for tobacco isolates of this species.
The disease was observed in the western hemisphere in Florida and Georgia around 1915, but it is thought that it took multiple introductions before it became established in the United States and Puerto Rico by 1925. The disease is now present in all tobacco-producing continents and in most major production areas with the notable exception of Brazil. In the 1930s and 1940s, the pathogen was introduced and became established in the major tobacco growing areas of North Carolina and Kentucky, and is now in all tobacco producing states of the US. Losses to the disease were often so high that tobacco could no longer be grown on a farm. This was the case until resistant varieties were introduced in the 1950s. A single source of partial resistance was used for many years in the management of this disease and is still the basis for resistance worldwide. Today, single-gene resistance also is widely deployed, but races of the pathogen have quickly appeared where single-gene resistance has been used. Chemical control was based on soil fumigants until the 1980s, when the fungicide metalaxyl was labeled for use on tobacco.
Selected References
Apple, J.L. 1962. Physiological specialization within Phytophthora parasitica var. nicotianae. Phytopathology 52:351-354.
Carlson, S.R., M.F. Wolff, H.D. Shew, and E.A. Wernsman. 1997. Inheritance of resistance to race 0 of Phytophthora parasitica var. nicotianae from the flue-cured tobacco cultivar Coker 371-Gold. Plant Disease 81:1269-1274.
Csinos, A.S. 2005. Relationship of isolate origin to pathogenicity of race 0 and 1 of Phytophthora parasitica var. nicotianae on tobacco cultivars. Plant Disease 89:332-337.
Csinos, A.S. 1999. Stem and root resistance to tobacco black shank. Plant Disease 83:777-780.
Erwin, D.C., and Ribeiro, O.K. 1996. Phytophthora Diseases Worldwide. American Phytopathological Society Press, St. Paul, MN.
Ferrin, D.M., and D.J. Mitchell. 1986. Influence of initial density and distribution of inoculum on the epidemiology of tobacco black shank. Phytopathology 76:1153-1158.
Hickman, C.J. 1970. Biology of Phytophthora zoospores. Phytopathology 60:1128-1135.
Johnson, E.S., M.F. Wolff, E.A Wernsman, W.R. Atchley, and H.D. Shew. 2002. Origin of the black shank resistance gene, Ph, in tobacco cultivar Coker 371-Gold. Plant Disease 86:1080-1084.
Jones, K.J., and H.D. Shew. 1995. Early season root production and zoospore infection of cultivars of flue-cured tobacco that differ in level of partial resistance to Phytophthora parasitica var. nicotianae. Plant Soil 172:55-61.
Kannwischer, M.E., and D.J. Mitchell. 1978. The influence of a fungicide on the epidemiology of black shank of tobacco. Phytopathology 68:1760-1765.
Lucas, G.B. 1975. Diseases of Tobacco. 3rd ed. Biological Consulting Associates, Raleigh, NC.
Shew, H.D. 1987. Effect of host resistance on spread of Phytophthora parasitica var. nicotianae and the subsequent development of tobacco black shank under field conditions. Phytopathology 77:1090-1093.
Shew, H.D., and G.B. Lucas. 1991. Compendium of Tobacco Diseases. American Phytopathological Society Press, St. Paul, MN.
Sullivan, M.J., T.A. Melton, and H.D. Shew. 2005. Managing the race structure of Phytophthora parasitica var. nicotianae with cultivar rotation. Plant Disease 89:1285-1294.